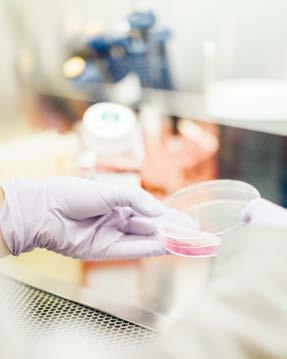

Director: Jorge Blanco Carvajal





Director: Jorge Blanco Carvajal


Por: Andrei Maldonado
Las intensas lluvias registradas durante junio permitieron que 14 municipios del estado hayan salido completamente de la sequía, esto de acuerdo al Sistema de Monitoreo de la Comisión Nacional del Agua (Conagua), con fecha de corte al 30 de junio. Los municipios que ya no están en sequía son: Coneto de Conmonfort, Guadalupe Victoria, Mapimí, Mezquital, Nombre de Dios, Pánuco de Coronado, Peñón Blanco, Poanas, Rodeo,
San Juan del Río, San Pedro del Gallo, Santa Clara, Súchil y Vicente Guerrero. El resto de los municipios ya están en los niveles más bajos de la sequía, ya ninguno en estado crítico, por lo que, de continuar lloviendo el resto de la temporada, los meses de julio a septiembre, se podría declarar por terminada la sequía en Durango, al menos en este ciclo 2025. En el nivel D0, es decir, anormalmente seco, y que es el menos severo de los niveles de sequía, están: Nuevo Ideal, Topia, Tlahua-
lilo, San Luis del Cordero, Pueblo Nuevo, Nazas, Lerdo, Hidalgo, Gómez Palacio, Cuencamé y Canelas; esto significa que casi abandonan la sequía.
En tanto que los municipios de: Durango, Canatlán, General Simón Bolívar, Guanaceví, Indé, Ocampo, El Oro, Otáez, San Bernardo, San Dimas, San Juan de Guadalupe, Tepehuanes, Tamazula y Santiago Papasquiaro están en el nivel D1 o sequía moderada.
Suman 150 casos los últimos años; en Jalisco y Zacatecas los mas recientes

Mónica Gutiérrez, coordinadora de Comisiones del Consejo Coordinador Empresarial (CCE) y expresidenta de la Asociación Mexicana de Agencias de Seguros y Fianzas (AMASFAC), aseguró que en los últimos años se han registrado 150 robos de vehículos que transportaban minerales.
La afectación, de consideraciones millonarias, se dio contra unidades pertenecientes a empresas mineras de Durango, aunque ocurridos en tramos carreteros fuera de la entidad, en donde los operadores han sido golpeados, atados e incluso ultimados.
Señaló que las pólizas del autotransporte se han incrementado en un 20 por ciento ya que se tiene un índice de siniestralidad del 22 por ciento en el traslado de materiales clase C, es decir, de alto riesgo, que incluye tanto minerales semiprocesados como residuos y sustratos. La entrevistada reconoció que
esto está sucediendo prácticamente en todas las carreteras del país, con especial incidencia en tramos en estados como Jalisco, Guanajuato, Zacatecas, Sinaloa, Estado de México y Michoacán, de ahí que las pólizas aumenten para circular esas vías. Por su parte Francisco Salazar Mendía, presidente de la Cámara Mexicana de la Industria de la Construcción (CMIC), reconoció que el reciente robo a los camiones de la empresa Mina de Bacís no es el único, pues en noviembre se robaron seis góndolas de otra empresa en Zacatecas. Indicó que esto se da porque los delincuentes se llevan el material, incluso los residuos, para procesarlo en otra parte y venderlo fuera del país, lo que está afectando seriamente al sector minero y pone en riesgo la llegada de nuevas inversiones de este tipo al estado y el país.

Interesados todavía pueden llevar sus casos a la Sala Regional Federal.
Entre ellos la capital y la región laguna: Tribunal Electoral
Son 18 los municipios del estado que continúan impugnados como resultado del pasado proceso electoral local para renovar sus alcaldías, entre ellos la capital y la Región Laguna, confirmó Blanca Maldonado Ayala, consejera del Tribunal Electoral del Estado de Durango (TEED).
En la más reciente sesión pública de resolución, el TEED confirmó la validez de la elección de los ayuntamientos de Nombre de Dios, Pánuco de Coronado, San Bernardo y Tepehuanes, reduciendo de 22 a 18 las impugnaciones levantadas por los partidos políticos que no ganaron.
Detalló que, aunque en el caso del municipio de Pánuco de Coronado se anuló la votación recibida en una casilla, ello no repercutió en los resultados
finales y únicamente se rectificó el cómputo y el orden de las regidurías asignadas, por lo que se procedió a dar la validez. Explicó que los interesados pueden todavía llevar sus casos a la Sala Regional de Guadalajara del Tribunal Electoral de la Federación; “con estas resoluciones, el Tribunal reafirma su compromiso con la legalidad, la transparencia y el respeto a los derechos político-electorales”, dijo.
Por otro lado, Maldonado Ayala agregó que, en la misma sesión, se desecharon tres medios de impugnación relacionadas con la elección del Poder Judicial local, ya que el inconforme, al no haber participado como candidato, carecía de interés jurídico para promover dichos medios impugnativos.

Con el compromiso de fortalecer la sostenibilidad ambiental en el estado, la diputada Mayra Rodríguez, del Grupo Parlamentario del Partido Acción Nacional (PAN), presentó la iniciativa que busca reformar la Ley de Cambio Climático del Estado, con el objetivo de integrar el concepto de compras verdes y establecer su implementación como una política obligatoria en las dependencias del Poder Ejecutivo.
Durante su intervención en tribuna, la legisladora subrayó la urgencia de adoptar prácticas responsables desde el gobierno, señalando que las compras verdes no son una tendencia pasajera, sino una necesidad urgente para garantizar un futuro saludable y sostenible para las próximas gene-
raciones. "Al adquirir productos y servicios con menor impacto ambiental, no solo reducimos nuestra huella ecológica, sino que impulsamos la innovación y la economía verde, promoviendo empleos y un mercado más competitivo y consciente", puntualizó la Diputada.
Explicó que la iniciativa contempla incluir en el glosario de la Ley de Cambio Climático la definición de compras verdes como la adquisición de bienes, productos o servicios que minimicen los impactos ambientales a lo largo de su ciclo de vida —desde la extracción de materias primas hasta su disposición final—, priorizando la eficiencia energética, el reciclaje y la reducción de residuos.

Asimismo, propone establecer como obligación para todas las dependencias y entidades del
Poder Ejecutivo implementar acciones y políticas orientadas a las compras verdes, asegurando que
los recursos públicos se utilicen de manera eficiente y responsable.
Otro punto relevante de la propuesta es conferir a la Secretaría de Recursos Naturales y Medio Ambiente del Estado la facultad de coordinar la aplicación de estas políticas entre las distintas dependencias estatales, garantizando una estrategia integral y coherente en materia ambiental. "La adopción de compras verdes representa una decisión ética, económica y socialmente responsable. Es una oportunidad para alinear el desarrollo con la protección del entorno y demostrar que el cambio comienza desde nuestras propias instituciones", concluyó la representante popular.
La secretaria de Turismo del Gobierno de México, Josefina Rodríguez Zamora, dio a conocer que, de enero a mayo de 2025, ingresaron a México 39.4 millones de visitantes internacionales, lo que representa un incremento del 14.2 por ciento respecto a 2024.
“Con estos resultados, México se continúa consolidando como uno de los destinos más atractivos y dinámicos en el mundo, así como una pieza fundamental para llevar bienestar a las y los mexicanos que participan de esta noble actividad. El turismo en México es una ventana que permite al mundo conocer, además de nuestra gastronomía, cultura y atractivos naturales, nuestra calidez, nuestra diversidad, creatividad y amor por nuestras raíces” manifestó.
Destacó que, de acuerdo con los resultados de la Encuesta de Viajeros Internacionales publicados por el Instituto Nacional de Estadística y Geografía (Inegi), el ingreso de divisas por visitantes internacionales durante los primeros cinco meses del año fue de

15 mil 929.5 millones de dólares, lo que representa un aumento del 6.4 por ciento respecto al mismo periodo de 2024 y del 43.8 en comparación del 2019.
Asimismo, enalteció que, tan solo en el mes de mayo, ingresaron al país 7 millones 938 mil 444 visitantes, 18 por ciento más
Añadió que el ingreso de divisas por concepto de turistas internacionales fue de 14 mil 624.1 millones de dólares, cifra 5.2 por ciento mayor que la del año pasado y 44.4 por ciento superior a la de 2019.
Ciudad de México (Agencias).- El desarrollo y la colocación de la vivienda vertical en el país se topó con una realidad del mercado durante el 2024 y es que la venta de este tipo de unidades tuvo un retroceso de 1.6% anual respecto al comportamiento del 2023, debido a que la oferta en ciertas ciudades no está alineada con la demanda de este modelo. La firma 4S Real State presentó su Gran Reporte de Verticalización 2025, donde se registra que
durante el 2024 se desplazaron cerca de 50,000 viviendas verticales, un ligero retroceso respecto al año previo, lo que refleja una realidad: la necesidad de recalibrar este tipo de producto hacia el grueso de la demanda.
“El verdadero problema no es la falta de demanda, sino la falta de producto alineado al poder adquisitivo real del comprador. Los desarrolladores han concentrado su oferta en segmentos altos y tickets premium, mientras que
En Durango, es el diario publicado por Editorial Contacto hoy, S. A. de C. V., todas las tardes de lunes a sábado, en la ciudad de Durango, Dgo., México. Fundado el 30 de enero de 1998. Impreso en Talleres, Oficinas y Redacción ubicados en: Blvd. Armando del Castillo Franco No. 820, Fracc. La Loma, C.P. 34058. Tels: 128-0717 y 128-0647. Correo electrónico: contactohoy@prodigy.net.mx. Web: www.contactohoy.com.mx
Jorge Blanco Carvajal Director General
Ricardo Güereca Reyes Jorge Adrián Blanco Barraza Jefe de Redacción Jefe de Información
Susana Blanco Barraza Erika J. Blanco Barraza Redes Administración
Reporteros: Martha I. Medina Valenzuela, Andrei Maldonado, Hugo Burciaga. Diseño: Arturo Navarrete
Asesor Jurídico: Miguel Ángel Ortiz Gallegos
Características 224 153703 autorizado por el Servicio Postal Mexicano. Reserva de Derecho al
exclusivo: 04-2018-101714083700-101 expedido por
Nacional del Derecho de Autor. Certificado de Licitud de Título y Contenido No. 17212 expedido por la Comisión Calificadora de Publicaciones y Revistas Ilustradas de la Secretaría de Gobernación.
que en el mismo mes de 2024, de los cuales 3 millones 751 mil 180 fueron turistas internacionales con pernocta y 4 millones 187 mil 264 fueron excursionistas. Del mismo modo, se registró un ingreso de divisas por visitantes internacionales de 2 millones 618.8 millones de dólares, es decir 6.3 por ciento más a tasa anual.
La titular de la Secretaría de Turismo (Sectur) refirió que, de enero a mayo, 19.4 millones de turistas internacionales ingresaron al país, 6.8 y 6.6 por ciento más que el mismo lapso de 2024 y 2019, respectivamente.
Frenada venta de vivienda vertical por desconexión entre oferta y demanda
los compradores están buscando opciones entre 1.8 y 4 millones de pesos. Esa brecha la está resolviendo el mercado de reventa, no la oferta nueva”, explica Ignacio Torres, director general de 4S Real Estate.
Para Adrián Hidalgo Reynoso, director comercial de la firma, en algunas ciudades del país la oferta de vivienda vertical se ha concentrado en unidades con un valor superior a los 6 millones de pesos, lo que indica que ciertas regiones no responden a la demanda que busca hogares de menor precio.
Ante la falta de oferta de viviendas verticales nuevas más accesibles, el mercado secundario ha tenido un crecimiento importante. Según los datos del reporte, las operaciones de reventa crecieron 19.6% durante el 2024.
Según la firma, este comportamiento revela un desajuste estructural: el mercado no se contrajo, sino simplemente se redistribuyó, principalmente a que gran parte de la oferta nueva no responde al perfil de demanda más activo.
En general, la vivienda vertical ha tenido un buen comportamiento en los últimos años. De acuerdo con los registros de la firma, entre el 2017 y el 2024, el inventario de este tipo de hogares
creció 213% a nivel nacional.
Ante el crecimiento poblacional de las ciudades, se comienzan a ver más edificios de vivienda vertical en urbes donde no se había detonado el modelo. Según el director comercial de 4S Real Estate, la necesidad de vivir cerca de los centros de trabajo hace que crezca la demanda de este tipo de hogares.
“Obviamente hay ciudades ya totalmente verticalizadas como Ciudad de México, Mon-
Expuso que, en este mismo periodo, llegaron a México 10.2 millones de turistas de internación vía aérea, con un gasto medio de mil 300.5 dólares, lo que representa un incremento de 6.8 por ciento respecto a 2024 y de 24.7 en comparación con 2019. Por otra parte, Rodríguez Zamora señaló que, durante los primeros cinco meses del año, arribaron a los diferentes puertos de México cinco millones de pasajeros vía crucero, lo que representa un aumento de 10 y 19.5 por ciento en comparación con 2024 y 2019, respectivamente. En este tenor destacó que el ingreso de divisas generado por estos excursionistas en cruceros ascendió a 427.7 millones de dólares, cifra 12.0 por ciento superior a la registrada en 2024 y 48.4 por ciento mayor que en 2019.
terrey y Guadalajara y seguirán con esta tendencia… pero vienen ciudades emergentes en donde empezamos a ver que se empiezan a verticalizar y que empiezan a tener estos edificios”, declaró Reynoso. De acuerdo con el reporte, urbes como Mérida, Mazatlán, Puerto Vallarta y Tulum— todas con vocación turística— son localidades donde la demanda de vivienda vertical ha crecido de manera importante.



Lamentable, y mucho, que la presidenta Claudia Sheinbaum lleve dos días respondiéndole al abogado de Ovidio Guzmán, Jeffrey Lichtman, sobre sus acusaciones, pero la principal, que ella actúa como vocera de los cárteles.
Nadie sabe si Jeffrey está actuando de manera personal, pero aunque no estuviera haciéndolo por sí solo, no es él quien debiera hacer tales señalamientos.
Es un simple abogado, no es ninguna autoridad en la Unión Americana como para tener que responderle. Tiró el anzuelo, lo mordió el gobierno federal, cuando ni siquiera debió responderle.
Alejandro Gertz Manero, el fiscal general de la República, también criticó al litigante. Lo tachó de oportunista, irrespetuoso y farsante que no deja de ser parte de la delincuencia.
El problena es, decía, que no esté actuando por sí solo, sino que esté siguiendo algún dictado del gobierno de Donald Trump, porque ni al caso venía mencionar al general Salvador Cienfuegos, al que acusan de ligas con los cárteles, confirmado, que fue extraditado a México y acá el gobierno lo perdonó.
Si el abogado está entregando el mensaje de Estados Unidos, malo para nuestras autoridades, porque se redujeron hasta el nivel de un postulante y por lo mismo cuestionable, y no han quedado del todo bien.

Y si el dicho de Lichtman es el mensaje del gobierno vecino, malo, porque es un adelanto de lo que ya confesó Ovidio Guzmán que puede enlodar de manera irreversible al ex presidente Andrés Manuel López Obrador, al Andy, a gobernadores y a funcionarios federales. Es que Jeffrey no es nadie
como para reclamar el perdón a Cienfuegos y ni siquiera se le debe responder, pero si es el enviado de la autoridad norteamericana, algo grande va a pasar acá. La semana, no obstante la paz y tranquilidad de Durango, está saliendo cargada de rumores entre los que destacan “la presencia acá de agentes de la DEA…”, o la otra, el importante volumen de agentes de la Interpol que ya tienen varias semanas entre nosotros. Rumores van y vienen, incluyendo casos de informes que aseguran que el personal externo está en esta o en aquella casa, pero las horas transcurren en relativamente calma.


No está bien informada la fiscal Sonia Yadira de la Garza sobre nuestra denuncia ante la Comisión Estatal de los Derechos Humanos. En nuestra queja pusimos nombres y apellidos, pero la CEDH, en su papel de defensora estatal, turnó la queja ante la Fiscalía. El cuento viene a la escena por la respuesta que dio la Fiscal a los reporteros que la interrogaron (inconfundiblemente movidos por Prensa) sobre la mortífera balacera del jueves antepasado. Tanto ella como el secretario de Seguridad, Óscar Galván, siguiendo las mismas directrices estatales, salieron a negar el tiroteo en el que testigos aseguran que se hicieron unos 500 disparos, pero “se cree que fueron disparos al aire…”, dijo Galván, y cosa parecida la Fiscal.
Sin embargo, ella precisó que “no digo nada sobre ese medio porque me denuncian ante la CEDH. Ahí quedó confirmada la nueva modalidad de persecución estatal a Contacto Hoy: Los reporteros haciendo la misma pregunta de que si hubo la balacera como “un medio lo informó…”. Es que ese medio, el único que estuvo en el terreno de los hechos, es Contacto Hoy, pero ellos empeñados en negarlo todo. Ya se han olvidado un poquito de los trolles, pero ahora están usando a los reporteros y medios afines para cuestionar e intentar ridiculizar nuestra tarea. No será sencillo, pero para lograrlo tendrán que ponerle un poquito más. Tienen que meterle algo de enjundia y un mucho de imaginación, que no abunda entre los compañeros, con tal de conservar la aviaduría y la esplendidez estatal.
se “esfumaron” en unos 120 minutos, cuando mucho, y no quedó ni rastro del material rocoso. El caso es que mucho se está rumorando del caso, pero como acá somos serios, nada más podemos decir que según el mundo del hampa, en “jale limpio no admite reclamación…”.
Y si la carga no aparece por ninguna trituradora, tampoco podemos sostener que el monto de lo robado ande por los 1,500 millones de pesos, pesos más, pesos menos, según estimaciones conservadoras de los que saben de eso.

Y saben qué, ya probamos la libertad periodística y…nos gustó. Nuestros proyectos (¿) ahora están enfocados en lograr la sobrevivencia a pesar de la enfermiza búsqueda estatal de exterminio.
El problema para nuestros detractores está en que, el tiempo sigue pasando y cada día son más miles de seguidores que nos mantienen por encima de todos. Y no abundamos en datos, porque también eso les molesta, además sería como enseñar nuestras armas.
La gente no es tonta, tonto es el que piensa que la gente es tonta, y sabe que somos el único periódico con información y reacciones reales, verificables y por eso nos prefiere por encima de quien se ponga el saco.
Preferimos eso, la confianza de nuestros lectores, porque saben que acá publicamos la nota sin maquillaje o sin censura, que van los datos tal cual, como ocurrieron los hechos.
En ocasiones nos falla, somos humanos, pero por lo general lo publicamos hasta que está certificado, hasta que tenemos la seguridad de que ocurrió.

Hasta el momento, las lluvias que se han presentado en esta ciudad y en algunos puntos del medio rural han tenido efecto positivo en el estado de ánimo de la gente del campo, pues se renueva la esperanza de que las cosas mejoren tanto para la agricultura como la ganadería. En el caso de los productores del campo, el hecho de que ya se hayan registrado lluvias en los últimos días, desde junio para ser más precisos, renueva la esperanza de que se puedan tener mejores condiciones para las zonas de cultivo.

Sobre el ahora identificado como “El Robo del Siglo”, seguimos igual que la Guardia Nacional y la Fiscalía de Jalisco. Es un puro e inconfundible “jale limpio…”. Las supuestas 33 toneladas de concentrado de oro y plata
Aunque estas precipitaciones levantan el ánimo de los campesinos, todavía falta que continúen y sigan constantes en julio y septiembre y sean más generalizadas, pues hay muchas partes donde todavía no llueve como se quisiera. Es necesario esperar a que se cumplan los pronósticos de que los próximos días seguirán generalizarse las lluvias, lo cual permitiría resolver el tema del abastecimiento de agua para la población, para el ganado y para que haya forraje disponible para los animales. Se espera que sea un año bueno para la producción del campo, que las suficientes lluvias lo permitan, pero esto todavía no se sabe, porque el ciclo agrícola apenas inicia…
El prometedor encuentro se escenficará en el Metlife Stadium, de New Jersey, por ahí de la 1:00 de la tarde de mañana domingo. No sabemos las razones para que sea allá, pero bien pudo ser en Los Ángeles, Miami y hasta en Chicago, donde hay más soccer.
Sin duda, los dos finalistas son los que hicieron los méritos para llegar hasta la cima, y como se trata de dos conjuntos grandes, las apuestas están encontradas.
Nosotros, sin irle un quinto, vamos al Chelsea porque trae mejores indivualidades, pero el PSG no es ninguna pera en dulce, es nada más y nada menos que Champion Ligue, y con eso queda garantizado el espectáculo. Si Dios me lo permite, no me lo pierdo.

La final del Mundial de Clubes, el primero en ese formato y en una sola sede, Estados Unidos, se juega mañana ente el Chelsea de Inglaterra y el París Saint German.
No son buenos los informes que vienen de los Estados Unidos respecto al maltrato de los indocumentados. Las fuerzas federales le han cargado la mano a las ciudades santuario como Los Ángeles y Nueva York, donde están cargando con lo que encuentren. Aquello de que el origen del movimiento es la necesidad de echar fuera a los delincuentes se está diluyendo, porque esta semana, según recuentos, han llegado elementos del ICE hasta diversas granjas de las afueras de la urbe angelina y se han llevado cientos de trabajadores. Los daños en la agricultura y ganadería son irreversibles. Los granjeros ya hicieron todo lo que está en sus manos para que no se vayan los trabajadores, pero el gobierno se ha montado en su macho y quiere lo más alejados posible a los indocumentados, así se pierda lo que se pierda en la producción.
Ciudad de México (La Jornada).- La ciencia, la educación superior y la innovación deben siempre situarse en el centro del diálogo político y estratégico, y más aún en periodos de crisis, aseguraron autoridades de gobierno y universitarias, así como representantes diplomáticos que participan en la Tercera Cumbre Académica y del Conocimiento Celac-UE, “Consolidando el espacio común de educación superior, ciencia, tecnología e innovación”.
En la reunión, que se realizó en la Ciudad de México, Francisco André, embajador de la Unión Europea en México, precisó que la cooperación académica y científica son herramientas poderosas para fortalecer las democracias, fomentar el entendimiento mutuo y construir sociedades más equitativas y libres. El diplomático expuso que el congreso se efectuó en un momento clave, antes de la cumbre de jefas y jefes de Estado Celac-UE de noviembre próximo, y aseguró que la Unión Europea continuará trabajando e impulsando iniciativas que fortalezcan la integración educativa, la cien-
cia abierta, la investigación colaborativa y la innovación social. Ricardo Villanueva Lomelí, subsecretario de Educación Superior de la Secretaría de Educación Pública, acotó que en un contexto de policrisis como el que vivimos, se requiere replantear el rol del conocimiento y la ciencia para afrontar los desafíos y en el caso de México se deben cambiar ciertas realidades como la dificultad para revalidar estudios. Dio a conocer que en la administración de la presidenta Claudia Sheinbaum se busca que todas las universidades mexicanas tengan un espacio común. Rosaura Ruiz Gutiérrez, titular de la Secretaría de Ciencia, Humanidades, Tecnología e Innovación, habló de los rezagos en materia de admisión a la enseñanza superior. Sólo tres de cada 10 jóvenes de entre 18 y 22 años tienen acceso a una licenciatura, de los cuales dos están en una institución de educación pública. Si se toman en cuenta todas las edades, la cobertura es de 43.8 por ciento, y destacó que por ello en el actual sexenio se busca ampliar la oferta de estudios universitarios.v

El secretario de Educación Pública, Mario Delgado Carrillo, informó que concluyó con éxito la Consulta Nacional para Estudiantes de Bachillerato, un ejercicio inédito de participación estudiantil que logró recabar 577 mil 226 opiniones de alumnas y alumnos de todo el país, superando por más del doble la meta inicial.
Delgado Carrillo destacó que este esfuerzo, impulsado por la Subsecretaría de Educación Media Superior (SEMS), a cargo de Tania Rodríguez Mora, contó con el apoyo de la Asociación Nacional de Universidades e Instituciones de Educación Superior (Anuies) y forma parte de las acciones promovidas por la Presidenta Claudia Sheinbaum Pardo para fortalecer este nivel educativo. Explicó que la consulta se realizó del 19 de mayo al 7 de julio de 2025, mediante un cuestionario en línea distribuido por autoridades educativas federales y estatales, quienes colaboraron activamente en su difusión entre las y los estudiantes de bachillerato.
El titular de la SEP subrayó que la participación fue voluntaria, anónima y abierta a todas y todos los estudiantes de los distintos subsistemas y entidades federativas.
La Universidad Juárez del Estado de Durango (UJED), a través de la Dirección de Servicios Escolares, que encabeza Jorge Arturo Cisneros Martínez, y del abogado general, Gerardo Antonio Gallegos Isaís, llevó a cabo el “Curso de Capacitación sobre el Reglamento de la Dirección de Servicios Escolares y Situaciones Legales”, dirigido a directivos de todas las unidades académicas, con el objetivo de fortalecer sus conocimientos y habilidades en materia normativa y jurídica.
Durante su participación, Gallegos Isaís reconoció el liderazgo del rector Ramón García Rivera, destacando su interés por impulsar este tipo de iniciativas que fortalecen la comunicación institucional y consolidan la identidad universitaria.
“Es importante abrir estos espacios de diálogo sobre la reglamentación universitaria, que es la que debe aplicarse. La participación de los directivos permite esclarecer dudas, unificar criterios y recoger inquietudes que, en su momento, podrán reflejarse en los ordenamientos jurídicos, mejorando así nuestros procesos”, señaló. En la capacitación se abordaron los temas más relevantes y actuales del reglamento escolar y las

situaciones legales que enfrentan cotidianamente los responsables académicos y administrativos. El propósito fue proporcionarles herramientas prácticas para afrontar los desafíos normativos, garantizando así una gestión educativa eficiente, equitativa y con apego a Derecho. El ejercicio resultó sumamente enriquecedor, ya que los asistentes compartieron experiencias valiosas de sus respectivas unidades académicas, propiciando un intercambio de conocimientos y perspectivas que fortalecen la toma de decisiones institucionales.
Por su parte, Cisneros Martínez agradeció la presencia de los académicos y responsables del área de Servicios Escolares de cada unidad académica, y compartió información sobre el nuevo reglamento vigente, abordando temas clave como matrícula, ingreso y egreso de alumnos, bajas, calificaciones y ciclos escolares.
Con esta iniciativa, la UJED refrenda su compromiso con la excelencia académica y la formación integral de sus estudiantes, destacando la importancia de la capacitación continua para directivos y funcionarios universitarios.
Por su parte, la subsecretaria Tania Rodríguez Mora explicó que el objetivo fue conocer de primera mano las experiencias, necesidades y expectativas del estudiantado respecto a su paso por el bachillerato o la preparatoria. Agregó que, a través de una muestra no probabilística pero territorialmente amplia, se reunieron insumos valiosos para orientar el diseño de políticas públicas más pertinentes e inclusivas. Entre los temas abordados en el cuestionario destacaron: Percepción sobre la calidad educativa, obstáculos para acceder o continuar los estudios, modalidades educativas preferidas, necesidades de infraestructura, actividades extracurriculares y orientación vocacional, opiniones sobre una eventual Ley General de Educación Media Superior y participación diversa y representativa.
Rodríguez Mora señaló que la participación representa más del 10 por ciento de la matrícula nacional del ciclo escolar 2024-
2025 (estimada en 5.1 millones de estudiantes), con tasas de respuesta destacadas en entidades como el Estado de México, Jalisco, Veracruz, Hidalgo y Ciudad de México, así como en regiones rurales de Chiapas, Oaxaca y Guerrero, donde también se superaron ampliamente las metas previstas.
Detalló que participaron más mujeres que hombres, y que la mayoría de quienes respondieron tienen entre 16 y 17 años, aunque también hubo participación de jóvenes de 15, 18 y 19 años. Este ejercicio representa un paso sin precedentes en el reconocimiento de las juventudes como actoras centrales del sistema educativo. Los resultados serán sistemati zados y dados a conocer públicamente en las próximas semanas, como parte del proceso de construcción colectiva de una educación media superior más justa, flexible y de calidad.
Dan a conocer proyectos seleccionados de convocatoria “Escenarios IMSS-Cultura”
El Instituto Mexicano del Seguro Social y la Secretaría de Cultura del Gobierno de México, a través del Instituto Nacional de Bellas Artes y Literatura (Inbal), presentaron los resultados de la Convocatoria Nacional “Escenarios IMSS-Cultura”, en la cual se registraron más de 1,300 proyectos. A través de la convocatoria –que tiene como objetivo la activación de 25 teatros de la Red Teatral del IMSS con puestas en escena de calidad, así como la inclusión y el acceso gratuito para todas las audiencias– fueron seleccionados 100 proyectos.
De acuerdo con las postulaciones, se seleccionaron 36 proyectos de danza y 64 de teatro, provenientes de 28 estados: Aguascalientes, Baja California, Campeche, Chiapas, Chihuahua, Ciudad de México, Colima, Durango, Estado de México, Guanajuato, Hidalgo, Jalisco, Michoacán, Morelos, Nayarit, Nuevo León, Oaxaca, Puebla, Querétaro, Quintana Roo, San Luis Potosí, Sinaloa, Sonora, Tamaulipas, Tlaxcala, Veracruz, Yucatán y Zacatecas. Con un fondo de 30 millones de pesos para fortalecer la vocación social de la Red Teatral del IMSS y fomentar la consolidación de compañías independientes, a cada proyecto se le otorgarán 300,000 pesos para la presentación de seis fun-
ciones en dos espacios escénicos del IMSS distribuidos en siete regiones del país, para generar una mayor circulación de puestas en escena y diversificación de la cartelera.
Las funciones de “Escenarios IMSS-Cultura” están dirigidas a toda la familia y se presentarán en 25 teatros del IMSS ubicados en Aguascalientes, Baja California, Campeche, Ciudad de México, Durango, Estado de México, Guanajuato, Jalisco, Michoacán, Querétaro, San Luis Potosí, Sinaloa, Tlaxcala y Zacatecas.
La función de estreno tendrá lugar en agosto en la Ciudad de México, mientras que el resto de la programación tendrá lugar entre septiembre de 2025 y febrero de 2026.
El listado completo de los proyectos seleccionados se puede consultar en: escenariosimsscultura.inba.gob.mx y las carteleras de las funciones estarán disponibles en la página web del IMSS y del Inbal, así como en la página del Fideicomiso de Administración de Teatros y Salas de Espectáculos del IMSS (Fidteatros).
La Convocatoria Nacional “Escenarios IMSS-Cultura” fue posible gracias a la firma del convenio marco entre el Instituto Mexicano del Seguro Social y la Secretaría de Cultura del Gobierno de México, celebrada el 27 de marzo del 2025.
La diputada Gabriela Vázquez Chacón, del Grupo Parlamentario del PAN, alzó la voz en tribuna para denunciar con claridad lo que calificó como un intento de “espionaje legalizado” por parte del gobierno federal, luego de que el Senado aprobara una nueva Ley de Telecomunicaciones que facultaría a las autoridades a rastrear en tiempo real la ubicación de cualquier ciudadano, sin orden judicial y sin causa justificada.
“¿Dónde queda entonces el derecho a la privacidad? ¿Dónde queda nuestra libertad de movimiento y de pensamiento?”, cuestionó la legisladora.
Durante la sesión de la Comisión Permanente, recordó que originalmente se dijo que esta reforma era para frenar propaganda extranjera ofensiva contra los migrantes mexicanos, pero el dictamen publicado a las 10:30 de la noche resultó ser una ley comple-
ta de 310 artículos, de los cuales sólo tres trataban ese tema.
“Esto no es seguridad, esto es persecución preventiva”, señaló Vázquez Chacón. Advirtió que con esta reforma el gobierno tendría en sus manos una herramienta para espiar a periodistas, activistas, opositores y ciudadanos que simplemente piensen diferente. “Nos quieren hacer creer que esta medida es para nuestra protección, pero no es así”, agregó.
La diputada lamentó que mientras la delincuencia organizada sigue impune, el gobierno federal prefiera perseguir a ciudadanos inocentes. “Es más fácil espiar a todos que hacer justicia para todos”, dijo. Reiteró que Durango y México necesitan estrategias eficaces de seguridad y respeto absoluto a los derechos humanos, no leyes que siembren miedo.
“Defender la privacidad no

es defender a los delincuentes. Es defender a la democracia. Ningún gobierno tiene derecho a ponerle

Despliegan personal técnico, refuerzan vigilancia y protocolos internacionales.
La Secretaría de Agricultura y Desarrollo Rural (Agricultura), a través del Servicio Nacional de Sanidad, Inocuidad y Calidad Agroalimentaria (Senasica), informó las acciones que realizó, en el marco del protocolo de contención y erradicación del gusano barrenador del ganado (GBG), luego de que el 8 de julio se confirmó un caso de GBG en un becerro de un mes de edad en Ixhuatlán de Madero, municipio ubicado en la zona centro-norte del estado de Veracruz y a la fecha no se han presentado casos secundarios.
El director en jefe del Senasica, Javier Calderón Elizalde, explicó que de manera transparente y oportuna el organismo informó del caso a sus contrapartes del Servicio de Inspección Sanitaria de Plantas y Animales (APHIS, por sus siglas en inglés), a gobiernos estatales y a productores de la región.
“Desplegamos inmediatamente alrededor de 20 médicos veterinarios; establecimos acciones de control en el punto focal,
que es en donde tuvimos la detección de este caso, en el punto perifocal, desplegamos alrededor de 20 médicos veterinarios”, explicó. Calderón Elizalde destacó la liberación terrestre de moscas estériles de GBG por un periodo de al menos tres ciclos biológicos de la mosca, así como el reforzamiento de la vigilancia epidemiológica y el control de la movilización de animales en la región. “A la fecha, no hemos tenido casos secundarios, por lo cual nosotros consideramos esto como una incursión, y estamos seguros de que en no más de dos semanas el caso ya estará inactivo”, agregó. El Senasica inició la investigación epidemiológica en un radio de 40 kilómetros a la redonda del hallazgo, con el apoyo de personal federal, estatal y del Comité para Fomento y Protección Pecuaria del Estado de Veracruz. Mientas que el personal técnico visita todas las Unidades de Producción Pecuaria (UPP), traspatios, mercados de animales, centros de acopio de ganado, clínicas y consultorios veterinarios, con el
objetivo de verificar si hay otros casos en la región.
De igual manera, inició la colocación de trampas desde el punto focal, hacia el sur de Tamaulipas, el este de San Luis Potosí, noreste de Hidalgo y sur de Veracruz, a fin de saber si hay circulación de la mosca Cochliomyia hominivorax en la región.
Se intensificaron las acciones de difusión y capacitación en puntos de contacto para promover el reporte de sospechas en la región, principalmente en los estados de Tamaulipas, San Luis Potosí, Hidalgo y la zona norte de Veracruz.
Asimismo, se reforzaron las acciones de verificación e inspección en los puntos de control federal, así como los autorizados en los estados de Veracruz, Hidalgo, San Luis Potosí y Tamaulipas, además de que se establecieron mecanismos de inspección itinerante a través de volantas y se autorizó el establecimiento de corrales para la inspección y tratamiento de ganado.
Tanto Mercosur, solo con inicial mayúscula, como MERCOSUR son formas válidas de escribir el acrónimo de Mercado Común del Sur.
En los medios económicos es habitual leer «El acuerdo entre la UE y Mercosur ha sido uno de los temas centrales de la reunión», «¿Cuáles son los países del MERCOSUR?» o «Argentina se prepara para la convención del Mercosur». Tal y como se explica en la Ortografía de la lengua española, es frecuente y válido que los acrónimos (siglas que pueden leerse con naturalidad en español sílaba a sílaba) construidos a partir de nombres comunes se incorporen al léxico —ovni, sida, láser— y se escriban íntegramente en minúsculas, y en el caso de aquellos que provienen de nombres propios, si tienen cinco letras o más —Unicef, Unesco, Sareb—, se escriban solo con mayúscula inicial. Por lo tanto, los ejemplos iniciales son todos válidos.
un GPS a la dignidad”, concluyó Vázquez Chacón al refrendar el compromiso de su bancada para
seguir luchando por un México con libertad, justicia y límites claros al poder.

Se tienen más de 9,000 combatientes de los tres órdenes de gobierno.
El Gobierno de México, a través de la Secretaría de Medio Ambiente y Recursos Naturales (Semarnat) y de la Comisión Nacional Forestal (Conafor), rindió homenaje y reconoció la perseverancia, dedicación y esfuerzo constante de las más de 9,000 personas combatientes de los tres órdenes de gobierno que laboraron durante esta temporada crítica de incendios, en el marco de la conmemoración el 11 de julio del Día Nacional del Combatiente de Incendios Forestales.
En el evento, encabezado por la secretaria de Medio Ambiente y Recursos Naturales, Alicia Bárcena Ibarra; y el titular de la Conafor, Sergio Graf Montero, se honró la memoria de las 12 personas fallecidas en el cumplimiento de su deber este año y se realizó un homenaje al doctor Dante Arturo Rodríguez Trejo, pionero y referente nacional e internacional en el manejo integral del fuego, quien lamentablemente falleció en noviembre.
En su intervención, la titular del sector ambiental federal reconoció la destacada labor de las y los combatientes, “nos reunimos para honrar y celebrar a las y los combatientes que son indispensables en el sector ambiental porque arriesgan su vida en esta noble y excepcional labor. Nuestras y nuestros combatientes siempre han peleado por el cuidado de uno de los principales tesoros de nuestro país: los ecosistemas forestales, sin ustedes México simplemente no podría ser un país de vocación forestal, porque tenemos más de 138 millones de hectáreas de superficie forestal y más del 70% de nuestro territorio cubierto de bosques, selvas y manglares”.
Por su parte, el titular de la Conafor Sergio Graf Montero, con profundo respeto se dirigió a los combatientes y les mencionó: “A ustedes qué decir, a mí me da
un orgullo ser su colaborador en el trabajo, es una institución la Conafor formidable y ustedes son una pieza fundamental del trabajo de la institución en la protección de los bosques”.
“Hoy es un día importante de reconocimiento para todos aquellos que trabajan en el manejo del fuego, en el combate, pero también a aquellos que están apoyando en la línea de su suministro, los investigadores, las organizaciones civiles, este día es para conmemorar su trabajo, para nosotros es fundamental reconocer la importancia de su desempeño”, puntualizó.
Resaltó la cooperación y organización entre estados para combatir los incendios en la zona norte del país, así como las brigadas con los diferentes niveles de gobierno, “tuvimos un gran apoyo de la Secretaría de Marina en todos estos incendios, de la Defensa, de la Guardia Nacional y Conagua con el despliegue del equipo aéreo, que siempre fue fundamental para lograr la atención de estos incendios”.
También reconoció a los estados que han apoyado esta tarea tan importante y destacó que el combate a los incendios forestales no es responsabilidad exclusiva del Gobierno Federal, la Conafor o los gobiernos estatales; es un esfuerzo conjunto que requiere la participación de todos, incluyendo la colaboración internacional. En el acto se informó que la Red Mexicana de Manejo del Fuego diseñó una medalla al mérito en el manejo integral del fuego, que será otorgada anualmente a las personas que contribuyan en esta materia en México; la primera fue entregada de manera póstuma a los familiares del doctor Rodríguez Trejo. También se dieron reconocimientos a las dependencias y brigadas que participan de manera activa en la prevención y combate de incendios forestales.
Sábado 12 de julio 2025
Desde Culiacán, Sinaloa, la secretaria de Bienestar, Ariadna Montiel Reyes, destacó que en el Segundo Piso de la Cuarta Transformación las Pensiones y Programas para el Bienestar continúan y se fortalecen, ejemplo de ello, Salud Casa por Casa, que a la fecha ha visitado en sus domicilios a 1.5 millones de adultos mayores y personas con discapacidad.
Durante el inicio de la gira de trabajo de la Presidenta Claudia Sheinbaum Pardo, resaltó que Salud Casa por Casa será el programa más grande de prevención en el mundo.
“¿Por qué está en Bienestar? Porque Bienestar es la felicidad del pueblo y vamos desde este programa a generar la atención preventiva más importante del país y nuestra presidenta nos ha marcado el horizonte, Salud Casa por Casa será el programa más
grande de prevención en el mundo”, agregó en la inauguración de las nuevas salas de quirófanos en el Hospital Pediátrico de Sinaloa. En Sinaloa, sostuvo que, 800 mil personas reciben un Programa de Bienestar con una inversión social de 26 mil millones de pesos (mdp). “Decirles que, bajo el liderazgo de nuestra Presidenta, los programas se fortalecen y continúan los que ya estaban”. Ariadna Montiel agradeció la confianza de la población a los Programas para el Bienestar, que son un derecho gracias a la lucha del pueblo de México, por lo que en Sinaloa reiteró su compromiso de seguir trabajando por el bienestar de todas y todos: “primero los pobres será lo que sigamos teniendo como un principio en el gobierno de la Cuarta Transformación”.

El Instituto Nacional de Rehabilitación “Luis Guillermo Ibarra Ibarra” (INRLGII) de la Secretaría de Salud, consolidó su programa de cirugías ambulatorias sabatinas como parte de una estrategia de innovación operativa en beneficio de sus pacientes. El programa, cuya fase piloto se desarrolló entre octubre y noviembre de 2024 en el Servicio de Cirugía de Mano, ha demostrado ser una alternativa eficaz para ampliar la capacidad quirúrgica sin requerir inversiones extraordinarias. Su éxito ha permitido extenderlo a otras especialidades como Traumatología, Ortopedia Pediátrica, Cirugía de Columna, Oftalmología y Tumores Óseos. El director general del INRLGII, Carlos Pineda Villaseñor, explicó que esta estrategia forma parte de un esfuerzo integral para modernizar la operación del Instituto y responder a los desafíos actuales: “La pandemia y el envejecimiento poblacional nos
han obligado a repensar el modelo tradicional de cirugías. Este nuevo enfoque permite reorganizar bajo criterios de eficiencia y calidad, en línea con la visión del sector salud federal”.
Por su parte, el director quirúrgico del Instituto, Juan Antonio Madinaveitia Villanueva, detalló que la estrategia se basa en un análisis estratificado de la demanda, identificando procedimientos de complejidad media-baja que pueden realizarse de forma ambulatoria. Esta recategorización permite liberar hasta dos espacios quirúrgicos diarios durante dos semanas, lo que representa una reducción significativa en los tiempos de espera para cirugías electivas. Estas acciones se alinean con la política del secretario de Salud, David Kershenobich, quien ha señalado que la clave está en utilizar mejor los recursos disponibles y reducir eficientemente el rezago quirúrgico. El modelo impulsado
por el INRLGII demuestra que es posible ampliar la capacidad resolutiva del sistema sin comprometer la calidad en la atención médica.
A través de este programa, el pasado 28 de junio se llevó a cabo la primera jornada multimodal del esquema sabatino, en colaboración con el programa “Ver por México” y la Alcaldía Tlalpan, en la que se atendieron 37 pacientes oftalmológicos y se realizaron 19 cirugías ambulatorias de columna. Asimismo, el 5 de julio el Instituto programó ocho cirugías de tumores óseos bajo este esquema. El programa de cirugías sabatinas del INRLGII busca trascender su impacto institucional y convertirse en un referente en innovación organizacional. Su enfoque demuestra que es posible avanzar hacia un sistema de salud más eficiente, resiliente y centrado en el paciente, con base en mejoras internas.
La Facultad de Trabajo Social de la Universidad Juárez del Estado de Durango abre sus puertas a quienes estén interesados en cursar la Maestría en Intervención Social Gerontológica, un programa que surge ante la necesidad de atender las situaciones que enfrentan las personas mayores en México, especialmente en Durango, entidad que atraviesa un proceso de transición demográfica.
Perla Vanessa de los Santos Amaya, jefa de la División de Estudios de Posgrado, compartió detalles sobre este programa educativo, que tiene como propósito formar profesionales capaces de desarrollar proyectos innovadores, tales como programas de educación intergeneracional, así como promover la planificación del proyecto de vida desde etapas tempranas, fomentando una visión integral y proactiva del envejecimiento, y generando conciencia para las futuras generaciones. Esta maestría dará inicio en febrero de 2026, con una duración de dos años. Pese a los retos que enfrentan los programas de posgrado en el país, se mantiene un optimismo cauteloso respecto al impacto positivo que este programa puede generar, no sólo al formar profesionales competentes, sino también al atender una problemática social que afecta a toda la población. La facultad refrenda su com-

Necesario atender situaciones que enfrentan las personas mayores en México.
promiso con una educación de alta calidad y relevancia social, y la Maestría en Intervención Social Gerontológica es muestra de ello. Para el ingreso, los aspirantes podrán cumplir con los requisitos establecidos o bien cursar un diplomado propedéutico especializado, el cual se desarrollará del 5 de septiembre al 7 de noviembre de 2025, con un costo de $3000 pesos. Este diplomado está dirigido
a profesionales de disciplinas sociales, humanas y afines. Las sesiones se llevarán a cabo durante dos años, con clases los viernes de 16:00 a 20:00 horas, y los sábados y domingos de 9:00 a 14:00 horas.
Para mayores informes o aclaración de dudas, los interesados pueden comunicarse a la Facultad al teléfono 618 817 66 63, o bien escribir a los correos electrónicos: posgrado.fts@ujed.mx o coordinacion.fts@ujed.mx
Moderniza DIF Nacional espacios para atención, cuidado y esparcimiento de personas mayores

Invertirán 78 millones de pesos en rehabilitación de 16 inmuebles del país.
El Sistema Nacional para el Desarrollo Integral de la Familia (SNDIF) ha puesto en marcha una iniciativa para modernizar y dignificar los espacios dedicados al cuidado y esparcimiento de personas mayores en situación de vulnerabilidad. Con una inversión específica de 32 millones de pesos, el programa contempla la rehabilitación integral de cuatro Campamentos Recreativos y dos Centros Gerontológicos ubicados en diferentes regiones del país. Bajo la dirección de María del Rocío García Pérez, titular del DIF Nacional, el Programa de Mejora a la Infraestructura 2025 representa una inversión total de 78 millones de pesos destinados a la rehabilitación de 16 inmuebles del SNDIF. Esta iniciativa no solo busca mejorar las condiciones de vida de las personas mayores, sino también garantizar condiciones laborales dignas para el personal que dedica su trabajo al cuidado de esta población prioritaria. El Centro Gerontológico "Arturo Mundet" en la Ciudad de México tendrá una inversión de 1.42 millones de pesos para la renovación completa de la infraestructura que incluye: Sustitución integral del sistema de impermeabilización, renovación de acabados en pisos, muros y plafones, modernización del sistema de iluminación con luminarias eficientes, actualización completa de muebles sanitarios y renovación del sistema de ductos.
En el Centro Gerontológico "Vicente García Torres", en la CDMX, se aplicarán 14 millones de pesos en: Renovación total de sanitarios tanto para residentes como para empleados, trabajos especializados de albañilería en núcleos sanitarios, rehabilitación de la casa anexa y sustitución del sistema de impermeabilización dañado. Los campamentos recreativos del SNDIF representan una propuesta de desarrollo de capacidades y habilidades intelectuales, físicas, morales y socioafectivas. Durante su estancia niñas, niños, adolescentes, personas mayores y
personas con discapacidad participan en actividades recreativas diseñadas para promover su bienestar integral. Por lo que en el Campamento "Playa Aventuras", en Tulum, Quintana Roo, se destinarán 3.90 millones de pesos para mejoras en: sistema de impermeabilización, sustitución de pisos en cabañas y áreas administrativas, mantenimiento especializado de aplanados en muros, modernización de grifería en instalaciones sanitarias y actualización del sistema de iluminación exterior. En el campamento "Vicente Guerrero", en Ixtapa, Zihuatanejo, se invertirán 4.10 millones de pesos en: Modernización completa del sistema de iluminación exterior, mantenimiento integral de pisos y recubrimientos, renovación de aplanados interiores y exteriores en cabañas y mejoras en áreas administrativas. En el campamento "Revolución", en Bucerías, Nayarit, las intervenciones comprenden: renovación completa de muebles y acabados sanitarios, trabajos especializados de albañilería en núcleos sanitarios, rehabilitación de la casa anexa y sustitución del sistema de impermeabilización con inversión de 4 millones de pesos. El campamento "Heroico Puerto de Mazatlán", en Mazatlán, Sinaloa recibirá 4.90 millones de pesos para mejoras en: renovación completa del sistema de cancelería, modernización de la cerca perimetral con nuevos postes, barras y malla, reconstrucción de pisos y muros de mosaico y renovación del aplanado pulido en muros.
Esta inversión histórica del DIF Nacional representa un paso fundamental hacia la construcción de una política de cuidados más humana, digna e incluyente. Con esta iniciativa, el DIF Nacional reafirma su compromiso con la construcción de una sociedad más justa e inclusiva, donde cada persona, independientemente de su edad, tenga acceso a espacios dignos y servicios de calidad.
Raymundo Riva Palacio
Baje del avión al Doctor Muerte
Los sabotajes realizados por Hugo López-Gatell probablemente fueron parte de las vidas perdidas en la pandemia y el exceso de mortalidad, pero también dejaron en litigio 97 millones de dólares prepagados a COVAX.
Hugo López-Gatell, que enfrenta acusaciones penales en México por el manejo de la pandemia de Covid-19, está a punto de tomar el avión que lo lleve a Ginebra. La presidenta Claudia Sheinbaum le inventó un puesto y lo enviará como enlace de la representación de México en los organismos técnicos de las Naciones Unidas, ante la Organización Mundial de la Salud. No debe hacerlo.
Nueva información sobre su gestión como zar del coronavirus demuestra un sabotaje sistemático para evitar que llegaran con celeridad a México las dosis contra el virus. El probable resultado: la cuarta ola de coronavirus, que produjo que casi uno de cada dos mexicanos estuvieran infectados. López-Gatell no ha rendido cuentas por lo que hizo en la pandemia, mareando con zalamerías al entonces presidente Andrés Manuel López Obrador, encerrado en su ignorancia y proclividad por la anticiencia.
En abril de 2021, con siete mil 300 casos de infectados con el virus, en lo que fue la primera ola de la pandemia, López Obrador comisionó al secretario de Relaciones Exteriores, Marcelo
Ebrard, a buscar dosis para evitar los contagios. Optó por trabajar con la Organización de las Naciones Unidas y con mecanismos internacionales como COVAX, una iniciativa para acelerar el desarrollo y la producción de pruebas, tratamientos y vacunas contra el Covid-19.
Como parte de esa cooperación, México logró en octubre de ese año acceder a una amplia variedad de dosis en fase II, que actúan como escudos protectores –Pfizer, CanSino y AstraZeneca, entre otras–. Nunca llegaron. Tres oficios confirman el rechazo de la Secretaría de Salud a esas vacunas:
1.- El 1 de octubre, Martha Leticia Caballero, encargada del despacho de la Dirección General de Relaciones Internacionales de la Secretaría de Salud, notificó a Martha Delgado, subsecretaria para Asuntos Multilaterales, que era la operadora de Ebrard para negociar las vacunas, del rechazo –sin explicación alguna– de dos millones 707 mil 200 dosis adicionales de la vacuna de AstraZeneca y dos millones 386 mil 800 de Pfizer BioNTech que ofrecía COVAX.
2.- El 11 de noviembre, Caballero le informó a Delgado que
una nueva asignación de AstraZeneca a través del mecanismo, por un total de tres millones 912 mil vacunas, no sería aceptada porque contaba con “un excedente” de dosis adquiridas directamente a la empresa, “por lo que (existía) un riesgo de no tener población blanco para su aplicación durante la vigencia de su caducidad”.
3.- El 21 de diciembre, una vez más le comunicó Caballero a Delgado que no aceptaban la nueva asignación de AstraZeneca a través del mecanismo COVAX por un total de siete millones 833 mil 600 dosis, sin explicar tampoco las razones de la decisión.
De acuerdo con exfuncionarios con conocimiento de primera mano de las negociaciones de las dosis, López-Gatell rechazó la propuesta de Pfizer BioNTech por prejuicios, que obligó a México a negociar con prisas y bajo presión lo que hubiera en el mercado. En público, el zar del coronavirus decía que ese laboratorio había tenido grandes avances en su vacuna, pero había dificultades para adquirirlas por los costosos sistemas de congelación que requería para su mantenimiento.
En esos días también rechazó una oferta de vacunas de Moderna a precios muy accesibles, de acuerdo con personas que conocieron detalles de las pláticas, aduciendo que su tecnología era similar a la de Pfizer, por lo que serían redundantes.
México también tuvo acceso a las vacunas producidas por el laboratorio chino CanSino Biologics, que hizo pruebas de su dosis
en fase III en diciembre de 2021 en México, porque López-Gatell, de acuerdo con las mismas fuentes, había esgrimido argumentos xenófobos y retrasó su aprobación en Cofepris, pese a que habían entregado toda la información clínica.
Entre octubre y noviembre de 2021, la Secretaría de Salud, encabezada por Jorge Alcocer –que era una figura de piedra en el manejo de la pandemia– rechazó casi 17 millones de dosis de COVAX, que coincidieron con la cuarta ola de la pandemia, la más severa al tenerse que enfrentar la variante agresiva de Ómicron. El pico se alcanzó el 20 de enero de 2022, cuando el número de infectados llegó a 484 mil 398 casos por cada millón de mexicanos.
López Obrador intervino directamente para que López-Gatell levantara el bloqueo a CanSino, que ofrecía una sola dosis y sin necesidad de refrigeración, que se planeó aplicar a maestros y en las regiones más inaccesibles y vulnerables del país. El laboratorio trabajó durante 12 semanas para tener listas las dosis en su planta en Querétaro, mientras el zar del coronavirus continuaba alegando en las reuniones semanales en Palacio Nacional que les tomaría más de dos años tener una vacuna y que sería imposible terminar el proceso biológico en México. No fueron los únicos afectados por las decisiones de López-Gatell avaladas mayoritariamente por López Obrador. Según los exfuncionarios, el laboratorio chino Sinovac ofreció ayudar a
detener los contagios y la mortalidad infantil, además de generar barreras extra frente al Covid-19. López-Gatell, agregaron una vez más, se negó a autorizar su entrada, argumentando que era innecesario vacunar a los niños, y que las presiones para que se les aplicaran dosis antes de regresar a clases presenciales, provenía de un sector que quería mantenerse con actividades escolares remotas, que favorecían al negocio de las farmacéuticas que buscaban vender más dosis. En las reuniones de gabinete, mientras tanto, seguía llegando la información de muertes de niños. Los sabotajes realizados por López-Gatell problablemente fueron parte de las vidas perdidas en la pandemia y el exceso de mortalidad, pero también dejaron en litigio 97 millones de dólares prepagados a COVAX. Para entonces, su estrella empezaba a perder brillo. La entonces jefa de Gobierno de la Ciudad de México se enfrentó con él en el gabinete y persuadió a López Obrador de que su estrategia era equívoca. Con sus negativos creciendo, lo comenzaron a esconder de la opinión pública.
López-Gatell, que se ganó el mote de Doctor Muerte, estaba en el ostracismo hasta que lo revivió la presidenta con el nombramiento en Ginebra, que provocó fuertes críticas. No pagar esos costos y bajarlo del avión, que le granjeará aplausos y reconocimiento.

ble.
Leopoldo Gómez
El vacío opositor
La oposición está tan desacreditada que incluso la crítica pública ha dejado de prestarle atención. Nadie discute sus rutas, sus liderazgos, su futuro. Con menos de una semana de diferencia, en Estados Unidos y México se registraron dos triunfos presidenciales decisivos. En ambos países, los mandatarios impulsaron paquetes legislativos profundamente divisivos y los aprobaron con el respaldo de sus mayorías partidistas. En ambos casos, la oposición fue incapaz de frenarlos.
A primera vista, podría parecer que los demócratas están tan perdidos como el PRI o el PAN, que tampoco han logrado frenar las iniciativas presidenciales. En eso, la situación es similar. Pero ahí terminan las coincidencias. Los demócratas aún tienen futuro. En cambio, la oposición mexicana enfrenta un panorama mucho más sombrío.
En Estados Unidos, el llamado Big Beautiful Bill representa la consagración legislativa y presupuestaria de muchas de las prioridades del actual gobierno. Los
demócratas no pudieron incidir en el contenido del paquete, pero ya tienen en él una causa, una narrativa y un posible punto de anclaje para reorganizar su discurso rumbo a 2026. La ley, ampliamente impopular según diversas encuestas, recorta programas sociales y extiende beneficios fiscales a los más ricos.
Es cierto que el Partido Demócrata sigue desorganizado, dividido, atrapado en disputas internas. Aun así, los demócratas están vivos. No solo porque mantienen un debate interno vigoroso, sino porque siguen siendo un referente obligado para los medios. Todos los días se publican notas, análisis y columnas sobre sus disputas, desafíos y posibilidades. Basta abrir las páginas de The New York Times o The Washington Post para constatar que siguen siendo relevantes. La derrota de 2024 fue dura, sí, pero no terminal.
En México, en cambio, la oposición apenas da señales de vida. Durante el reciente periodo extraordinario de sesiones, el Congreso aprobó 16 reformas de alto impacto que, como lo han denunciado varios analistas y organizaciones no gubernamentales, abren la puerta al espionaje estatal, refuerzan la militarización de la Guardia Nacional y crean nuevos márgenes para la censura. Aunque el PAN y el PRI votaron en contra, su presencia en el relato público de lo ocurrido fue casi inexistente. No marcaron agenda ni ocuparon un lugar visible en el debate nacional. Apenas fueron mencionados en los editoriales o análisis de las reformas.
La oposición está tan desacreditada que incluso la crítica pública ha dejado de prestarle atención. Nadie discute sus rutas, sus liderazgos, su futuro. No hay, en los hechos, una vida política interior vibrante. En ninguno de los dos partidos hay autocrítica, debate interno ni replanteamiento ideológico o estratégico. Por eso, lo que ocurre dentro del PAN o del PRI no genera noticia alguna. Y eso es todavía más grave que perder una votación: es volverse invisible, irrelevante, prescindi-
La situación de Movimiento Ciudadano no es mucho mejor. MC continúa siendo un partido de figuras, con presencia regional y un rol ambivalente como oposición. A veces actúa como tal, pero en otras ocasiones se alinea con la ‘4T’ o incluso se le entrega, como ocurre en Nuevo León con Samuel García. Difícil imaginarlo hoy como una alternativa real al partido en el poder. La debilidad de estos partidos no es un problema exclusivo de ellos. También lo es para el futuro de la democracia en México. No sorprende que Morena busque seguir acumulando poder. Ese es el proyecto político que López Obrador planteó desde el inicio de su sexenio y que ha ido materializándose con los distintos planes “A”, “B”, “C” y, próximamente, “D”. Todo ello en detrimento de los contrapesos entre poderes y la equidad en la competencia electoral que exige una democracia representativa. Pero la oposición también carga con esa responsabilidad. Como gobiernos, el PAN y el PRI decepcionaron y generaron las condiciones para el ascenso de Morena. Ya en la oposición,
siguen metidos en el escándalo y han abierto ampliamente el espacio para la consolidación de un nuevo régimen de partido hegemónico en el que la cancha cada vez está más dispareja en su contra.
Revertir eso exige una oposición fuerte, con miras claras y con un proyecto alternativo que sea capaz de conectar con la gente. No es una tarea sencilla y, con los partidos opositores que tenemos, probablemente ni siquiera esté en sus planes. Sin ello, no hay nada que pueda frenar el impulso de Morena, salvo su propia implosión o un estallido de desencanto y protesta social. Esperar pasivamente un desenlace así, en lugar de articular un “Plan A” propio, es la forma más clara de renunciar a su papel. Y, sin embargo, ahí es donde estamos: en un punto muerto, lejos del escenario estadounidense, donde los demócratas, incluso derrotados, debaten, se reorganizan y se preparan para volver. Es seguro que ellos regresarán algún día a la presidencia. El PAN y el PRI, probablemente, no. Y Movimiento Ciudadano, quizá jamás la alcance.
Desde jugar al tenis hasta colorear, tener un pasatiempo puede ayudarte a vivir mejor y más tiempo.

Cuando eliges un hobby , ¿te planteas si no solo es divertido, sino también bueno para ti? Si no es así, la ciencia te lo explica: en los últimos años, innumerables estudios han demostrado que una amplia gama de pasatiempos ofrecen beneficios para la salud física y mental de quienes los practican. Un artículo científico de 2023 recopiló los resultados de cinco encuestas diferentes, todas ellas sobre la participación en aficiones y el bienestar mental de personas mayores de 65 años. Los estudios hicieron un seguimiento de más de 93 000 personas mayores durante un periodo de cuatro a ocho años en Estados Unidos, Japón, China y 13 países europeos. En todos los lugares, los participantes con aficiones reportaron menos síntomas de depresión y mayor salud, felicidad y satisfacción con la vida que los participantes sin aficiones. El pasatiempo específico importaba menos que la participación.
Hei Wan Mak, autora principal del estudio, y lectora y aficionada a los rompecabezas en su tiempo libre, afirma: “Los beneficios de los hobbies son universales en diferentes países y entornos culturales”.
Aun así, con tantos pasatiempos disponibles, la investigación puede recomendar opciones que son especialmente saludables. Aquí hay varias ideas sobre cómo aprovechar esa hora o dos extra en beneficio propio.
Los beneficios del ejercicio físico para la salud física y mental
Las ventajas del ejercicio para la salud podrían llenar muchos más artículos que este. Para las personas que se esfuerzan por ponerse en movimiento, los efectos pueden ser profundos.
El running, uno de los deportes más antiguos, es conocido por mejorar la salud cardiovascular. También ayuda a fortalecer los huesos y los músculos, controlar el peso corporal y reducir el riesgo de cáncer, entre otras ventajas. Las investigaciones demuestran que mejora el rendimiento académico de los niños y la función cerebral de los adultos mayores. Un estudio incluso sugiere que correr con regularidad puede combatir la depresión con la misma eficacia que los antidepresivos.
La natación es otro ejercicio para todo el cuerpo adecuado para personas de todas las edades. Al igual que correr, nadar mejora la salud cardiovascular, reduciendo el riesgo de sufrir un infarto o un derrame cerebral. También mejora la capacidad pulmonar y el metabolismo, y calma la inflamación y el dolor articular. El tiempo que se pasa en el agua libera las hormonas serotonina y dopamina en el cerebro, lo que puede mitigar los trastornos del estado de ánimo y aumentar la
función de la memoria.
Fuera de la piscina y en las pistas, el tenis es una actividad perfecta para mejorar la salud. Reduce el riesgo de obesidad y diabetes de los jugadores, al tiempo que aumenta su flexibilidad, equilibrio y fuerza muscular central. Los tenistas también presentan niveles más bajos de estrés, ansiedad y depresión. Publicado en 2018, el estudio Copenhagen City Heart Study siguió a miles de personas durante 25 años y descubrió que, mientras que los nadadores, corredores, ciclistas y futbolistas añadían unos pocos años a su esperanza de vida, los tenistas añadían casi una década.
Luego está el pickleball, el primo más joven y ruidoso del tenis. El deporte de más rápido crecimiento en Estados Unidos ofrece muchas de las ventajas del tenis, incluida la diversión de jugar con otros. Los estudios demuestran que el pickleball tiene un impacto positivo en la salud mental: reduce la sensación de soledad y aumenta la satisfacción con la vida.
Cultivar alimentos, comer sano y cocinar se relacionan con un mayor bienestar
La alimentación, al igual que el ejercicio, es fundamental para una buena salud. Preparar tus propias comidas es una forma eficaz de controlar lo que ingieres y obtener algunos beneficios menos obvios.
La jardinería permite a los niños ensuciarse las manos y, más tarde, les da la oportunidad de llenar sus estómagos con los frutos y las verduras de su trabajo. Los niños que cultivan un huerto desarrollan habilidades para la jardinería y para la vida, y se vuelven más concentrados y seguros de sí mismos.
Del mismo modo, se ha demostrado que la recolección mejora el estado de ánimo de los niños y les anima a comer de forma nutritiva. Estas aficiones son una inversión a largo plazo, ya que los estudios relacionan la exposición temprana a la naturaleza con una mejor salud mental en la edad adulta.
Después de cosechar alimentos frescos, es hora de entrar en la cocina. Las investigaciones demuestran que cocinar (seguir recetas, medir ingredientes, realizar varias tareas a la vez) reduce el estrés y estimula los lóbulos frontal y temporal del cerebro, que están asociados con la memoria y la función ejecutiva. En una revisión científica, cocinar en casa llevó a las personas a comer más fibra y proteínas y, entre las personas con diabetes y enfermedades cardiovasculares, a controlar mejor su peso.
Cómo el arte y la música ayudan a reducir la ansiedad
y la depresión
¿Cuándo fue la última vez que sostuviste un lápiz de colores o un rotulador?
Resulta que colorear no es solo para niños. Cuando se combina con la terapia convencional, la terapia del colorear puede reducir la ansiedad y la depresión de los adultos y aumentar las emociones positivas.
Estos efectos también se producen rápidamente: según un estudio, casi tres cuartas partes de los participantes se sintieron más seguros después de dedicarse al arte durante tan solo 45 minutos. Otro estudio relacionado descubrió que la creación artística reducía significativamente los niveles de cortisol, una hormona relacionada con el estrés, de los participantes.
Tocar o escuchar música también puede mejorar la salud al liberar endorfinas y dopamina.
Por otra parte, se sabe que la musicoterapia mejora la concentración de los pacientes y alivia condiciones negativas como el dolor o la fatiga. Para los más pequeños, los bebés, la música puede ser formativa, ya que ayuda a estabilizar su ritmo cardíaco y respiratorio y sus patrones de sueño, así como a ganar peso.
Los beneficios de salir al aire libre y disfrutar de la naturaleza
Una de las mejores cosas que puedes hacer por tu bienestar es simplemente salir al aire libre. Escapar temporalmente de nuestros hogares o, para los urbanitas, de nuestras ciudades, puede hacernos más sanos y felices.
En los últimos años, varios estudios han explorado (y National Geographic ha informado sobre ello) los beneficios de estar entre árboles, cerca de pájaros y bajo el sol. La naturaleza tiene el poder de reducir el riesgo de enfermedades mentales y mejorar el rendimiento cognitivo y la memoria. Fomenta una sensación de asombro que estimula el pensamiento creativo.
Cada vez son más los estudios que confirman lo que mucha gente sintió durante los confinamientos por la COVID: pasar tiempo en espacios verdes, como parques y bosques, o azules, como costas y ríos, es reconfortante.
Además de los beneficios psicológicos, estas experiencias pueden reducir la presión arterial y fortalecer el sistema inmunológico. Y cuando no solo visitas espacios verdes o azules, sino que también haces ejercicio en ellos, los beneficios pueden ser aún mayores. Así que sal a dar un paseo por el bosque o alrededor de un lago por la tarde o el fin de semana. Luego ve a casa y pon tu música favorita mientras preparas la cena. Llámalo un día de pasatiempos saludables.
Santoral: Nabor
Día del Abogado

Cada 12 de julio, México celebra el Día del Abogado, una fecha dedicada a honrar a aquellos profesionales que, con su conocimiento y ética, trabajan para mantener el orden y la justicia en la sociedad. Este día no solo es una oportunidad para reconocer la importancia de los abogados en el sistema legal, sino también para reflexionar sobre los desafíos y responsabilidades que enfrentan en su labor diaria.
Orígenes del Día del Abogado en México
El Día del Abogado en México se celebra desde 1960, gracias a la iniciativa del entonces presidente Adolfo López Mateos. La fecha fue elegida en conmemoración del primer curso de Derecho impartido en el país, el 12 de julio de 1553, en la Real y Pontificia Universidad de México. Desde entonces, cada año se reconoce el esfuerzo y dedicación de aquellos que han elegido esta noble profesión.
Importancia del abogado en la sociedad
Los abogados desempeñan un papel crucial en la defensa de los derechos humanos, la resolución de conflictos y la promoción de la justicia. Su labor va más allá de los tribunales, ya que también actúan como asesores en diversas áreas del derecho, como el derecho civil, penal, laboral, y empresarial, entre otros.
En un mundo donde las leyes y regulaciones son cada vez más complejas, los abogados son esenciales para interpretar y aplicar la ley de manera justa y equitativa. Además, su conocimiento y habilidades son fundamentales para garantizar que las personas y las organizaciones cumplan con sus obligaciones legales y puedan defenderse adecuadamente cuando sea necesario.
Tirant Lawyer Week: ¡Celebra el Día del Abogado con Tirant! Como editorial académica y jurídica líder en Iberomérica, desde Tirant valoramos profundamente la labor de los abogados y deseamos rendir homenaje a su dedicación. Por eso, del 8 al 15 de julio, queremos celebrar contigo el Día del Abogado en México con descuentos especiales en nuestras principales áreas: editorial, formación y tecnología jurídica. Editorial: 15 % de descuento en todo el catálogo Durante esta semana, adquiere tus próximas lecturas con un 15 % de descuento en toda la web editorial. Es el momento perfecto para ampliar tu biblioteca jurídica.
100 a. C. Nace Julio César, político y militar romano.
1530 El gobierno de la Nueva España prohíbe que los indígenas usen o posean caballos.
1536 Muere Erasmo de Rotterdam, humanista, filósofo, filólogo y teólogo holandés, autor de importantes obras en latín. Su ideal fue únicamente ético. Su obra “Elogió de la locura”.
1605 Se conocen en la Nueva España los primeros ejemplares de la obra de Cervantes de Saavedra: “Don Quijote de la Mancha”.
1679 Inglaterra se pone a la cabeza de la protección de las libertades individuales al aprobar el Parlamento el "Habeas Corpus Act".
1813 Nace Claude Bernard, médico y fisiólogo francés, considerado como el fundador de la medicina experimental.
1817 Nace Henry David Thoreau, escritor, trascendentalista y filósofo anarquista estadounidense. Además de uno de los fundadores de la literatura norteamericana, hoy día se le considera un pionero de la ecología y de la ética ambientalista.
1854 Nace el empresario estadounidense, George Eastman, fundador de la Eastman Kodak Company e inventor del rollo de película, que sustituyó a la placa de cristal.
1859 Desde Veracruz, el Presidente Juárez emite la Ley de Extinción de Ordenes Monásticas y Bienes Eclesiásticos.
1865 Muere el jurista Ponciano Arriaga, liberal potosino que participó en la redacción de la Constitución de 1857.
1876 Nace Max Jacob, escritor, poeta, dramaturgo y pintor francés. Su escritura se caracteriza por un humor que intenta entremezclar fantasía con su gusto por la parodia y por lo onírico.
1884 Nace Amadeo Modigliani, pintor y escultor italiano de la Escuela de París, cuya primer exposición en Paris fue cerrada por "inmoral".
1904 Nace Ricardo Eliécer Neftalí Reyes Basoalto, que será conocido como: Pablo Neruda, poeta chileno portador del premio Nobel de Literatura. Entre sus obras se encuentran “Crepusculario”, “20 poemas de amor” y una canción desesperada” y “Odas elementales”.
1904 Nace René Lacoste, jugador de tenis y empresario francés. Como jugador era conocido como “El cocodrilo” así que de eso tomó inspiración para la creación de la primera camiseta deportiva Lacoste en 1929.
1928 Muere en Estados Unidos, el mexicano, piloto aviador Emilio Carranza.
1934 Nace Gualberto Antonio Castro, actor y cantante mexicano; integrante y voz principal de "Los Hermanos Castro".
1962 En el Club Marquee de Londres (Reino Unido), los Rolling Stones ofrecen su primer concierto con Jagger, Richards, Jones, Stewart, Chapman y Taylor.
1986 Científicos llegan al Titanic hundido, para explorarlo.
1997 Nace Malala Yousafzai, en Mingora, Pakistán, es una estudiante, activista y bloguera pakistaní. Ganadora del Premio Nobel de la Paz en 2014 a los diecisiete años, se convirtió en la persona más joven en acceder a ese premio en cualquiera de las categorías que se otorga. Malala es conocida por su activismo a favor de los derechos civiles.
2006 La ciudad jalisciense de Tequila es nombrada Patrimonio Mundial por la Organización de las Naciones Unidas para la Educación, la Ciencia y la Cultura (UNESCO).
2010 Muere la cantante cubana Olga Guillot. Se hace popular con canciones como "Miénteme", "La gloria eres tú" y "Tú me acostumbraste".
2015 Muere el pintor dominicano Ramón Oviedo destaca por sus exposiciones las galerías de Arte Andrés, de Arte Moderno Santo Domingo, Meeting Point Art Center, de Arte Arawak, Museo Bellapart y Centro Cultural de España. Pintó murales en la Organización de los Estados Americanos (OEA) en Washington y la Unesco, en París, Francia.
Durango, Dgo.- En medio de la lluvia del viernes por la noche, una adulta mayor se desplomó afuera de un centro comercial de la zona oriente de la ciudad y, cuando personal médico la revisó, ya había muerto.
Se trata de una fémina de unos 70 años de edad, de complexión robusta, cabello corto cano y ondulado, morena clara y una estatura de 1.65 metros, entre cuyas pertenencias no había identificaciones.
Fue poco después de las 20:00 horas cuando clientes y personal de vigilancia de la tienda Ley Juventud, ubicada en la colonia Luis Echeverría, pidieron asistencia médica al notar el desplome de la fémina.
Al lugar llegó personal de la Cruz Roja Mexicana pero, al revisar su cuerpo, ya no encontró signos vitales, por lo que se notificó al Agente del Ministerio Público. Según se informó, cómo seña particular, la víctima tenía el ojo
izquierdo completamente blanco, por lo que suponen que tenía ceguera en el mismo. Al momento de la defunción portaba pantalón café de vestir, blusa de color rosa y un bolso de mano negro con flores moradas.
Durango, Dgo.- Un trabajador de una empresa de telecomunicaciones fue víctima de un robo de herramienta, que uno o más ladrones sustrajeron del vehículo que dejó estacionado en la vía pública.
El afectado es empleado de la empresa Teico, una compañía de servicios de telecomunicaciones afiliada a Teléfonos de México. Su nombre, Francisco Javier. Los hechos ocurrieron en el bulevar Dolores del Río, muy cerca del ISSSTE, cuando la víctima se encontraba en el interior del centro médico realizando una donación de sangre.
A media mañana, cuando salió, se encontró con que alguien había hecho “palanca” al cristal trasero del automóvil Chevy y que se llevaron taladros, equipo de medición y herramientas de corte especializadas. De inmediato llamó al número de emergencias, pero se trataba ya de un hecho consumado probablemente horas antes, pues estaba dentro del centro médico desde las 6:00 horas y ya eran después de las 10:00. Ante ello, se le dieron los pasos a seguir para interponer la denuncia correspondiente ante el Agente del Ministerio Público.



Durango, Dgo.- Molesta por los conflictos entre su hermana y su ex cuñado, una mujer decidió ir de madrugada a la casa del varón para lanzarle desde la calle una serie de insultos que despertaron a todo el vecindario.
El afectado decidió llamar al número de emergencias y poco después llegó la Policía Municipal, a cuyos elementos la fémina también agredió, por lo que terminó arrestada.
La protagonista del incidente es Dalmy A., una joven de unos 25 años de edad que terminó a disposición del Juez Cívico por alteración del orden público y por
impedir a los oficiales su labor. Fue a eso de las 1:30 horas de la madrugada de este sábado cuando la joven mujer llegó a bordo de un Chevrolet Aveo frente al domicilio de Efraín, ubicado en la calle Beatriz Prado de la colonia Benjamín Méndez, y comenzó con los insultos. Cuando los agentes llegaron también a ellos les lanzó algunos recordatorios e incluso se resistió al arresto; al final la controlaron, pero no eludió su ingreso a una celda de la Estación Norte de la Dirección Municipal de Seguridad Pública.

Durango, Dgo.- Un sujeto de 49 años de edad derribó a golpes a un par de jóvenes de 19 y 24 en medio de un conflicto entre hermanos relacionado con la posesión de un domicilio; una de las víctimas fue hospitalizada.
Los lesionados son Noé Usiel D., de 19 años de edad (sobrino del agresor) y su cuñado, Guillermo R., de 24, quien se metió al pleito para defenderlo y terminó como el más golpeado. Su atacante es Jesús H. C., de 49 años, quien se dio a la fuga.
Los hechos ocurrieron durante la madrugada de este sábado en la colonia Miramar, un asentamiento de la zona oriente de la capital, ubicado a un costado de la colonia Jardines de Cancún.
Ahí, el ya mencionado agresor tuvo una discusión con su hermana Nayeli en relación a la posesión de una casa que ni siquiera es de ellos, pues la propietaria es la madre de ambos.
La disputa subió de tono y el hijo de la fémina enfrentó a su tío, que pudo con el otro muchacho, que acabaron en el suelo; ambos fueron atendidos por personal del Sistema Estatal de Emergencias Médicas, que determinó la necesidad de hospitalizar a Guillermo.


Durango, Dgo.- La intervención de un adolescente y el uso de un cojín para defenderse, evitó que una joven de 26 años de edad fuera acuchillada por su cuñado en medio de una violenta agresión ocurrida en la colonia San Carlos. Policías municipales que recibieron el reporte del ataque reac-

En sala Fidem, se veló el cuerpo de la Sra. Irene Ruiz Mendez, sus honras fueron en la Capilla de Funerales Hernández a las 13:00 hrs., y se despidió en el panteón Valle de los Cedros.
En Sala Clasíca A se está velando el cuerpo del Sr. Roberto Antonio Villalobos Flores, sus honras son en la Capilla de Funerales Hernández a las 15:00 hrs., y se despide para su cremación.
En sala Ad Regnum Dei se está velando el cuerpo del Sr. Humberto Ávila Hermosillo, sus honras son en el Templo Santa Cruz a las 14:00 hrs., y se despide en el panteón Valle de los Cedros.
En capilla Verona, Sucursal Casa Lomas, se está velando el cuerpo del Sr. Manuel Ramón Espinoza Arjón, de 55 años, sus honras y sepelio están pendientes.
En capilla #3, Matriz 5 de febrero, se está velando el cuerpo del Sr. José Ontiveros Nevárez, de 81 años, sus honras y sepelio están pendientes.
cionaron y detuvieron al sujeto, que ya está en manos de la Fiscalía General del Estado.
El asegurado es Éver Leonel L., de 26 años de edad, cuyo aseguramiento ocurrió en la calle San José del mencionado asentamiento, lugar en donde agentes lo desarmaron y aseguraron un cuchillo de cocina.
Según el informe, los hechos ocurrieron el viernes cuando el individuo estaba aparentemente intoxicado con drogas, lo que provocó que se tornara agresivo contra su propia madre.
Tanto la señora de 53 años como Blanca, cuñada del tipo, intentaron calmarlo pero se abalanzó contra ambas; a su progenitora la lanzó contra una pared y a la joven mujer sobre un sofá.
Además de darle un par de puñetazos a su cuñada, Éver sacó un cuchillo e intentó enterrarlo en su abdomen, pero ella se defendió usando un cojín, en el que el arma acabó enterrada.
Gracias a la intervención de un adolescente se logró contener al individuo y poco después llegó la policía para evitar que la situación pasara a mayores; el sujeto ya está bajo el resguardo del Agente del Ministerio Público.
En calle República de Uruguay #504, col. Francisco, Zarco, Pánuco de Coronado, Dgo., se está velando el cuerpo de la Sra. Martina Arreola Nájera, de 56 años, sus honras son en el Templo San Francisco de Asis a las 13:00 hrs. y se despide en el panteón Garrido.
En domicilio conocido, Loc. El Pino, Dgo., se está velando el cuerpo de la Sra. Mariana Ruiz Gutiérrez, de 59 años, sus honras y sepelio están pendientes.


Guadalupe Victoria, Dgo.- La Fiscalía General de la República aseguró, en el municipio de Guadalupe Victoria, un predio en el que se almacenaba irregularmente combustible; ante la presunción de un delito, el lugar quedó bajo el resguardo de la autoridad federal.
De acuerdo a lo informado por la instancia, fue mediante un cateo que se inspeccionó un predio ubicado en el tramo carretero
Francisco I. Madero - Guadalupe Victoria, en territorio de esta última municipalidad. Ahí, al revisar el inmueble como parte de una investigación federal, detectaron un tanque para 10 mil litros que, al ser revisado, resultó con alrededor de 2 mil 800 litros de diésel en su interior. Este contaba con una bomba dispensadora con manguera y botones para el funcionamiento
de Lerdo.
Lerdo, Dgo.- Un individuo logró escapar de las autoridades tras ser detectado ofreciendo droga a la venta en la vía pública; sin embargo, abandonó el enervante en la calle. Cuando revisaron, las autoridades encontraron más de 100 raciones de metanfetamina.
El presunto narcomenudista no fue identificado, pero se informó que huyó a través de una zona de baldíos cercanos a la colonia San Juanito del municipio
Los datos difundidos por la Secretaría de Seguridad Pública del Estado indican que fue en un recorrido conjunto de Policía Estatal, Ejército Mexicano y Guardia Nacional que se observó al individuo a la distancia.
Cuando éste se percató de la presencia de la Fuerza Metropolitana, se echó a correr pero fue imposible alcanzarlo; no obstante, abandonó una mochila de co-

lor azul adornada con lentejuelas. Al revisar a detalle se encontró dentro 76 raciones de metanfetamina y 23 más de marihuana. Además, había tres cigarrillos de este enervante, al parecer también con fines de venta.
Todo fue embalado y entregado al Agente del Ministerio Público para que se integre la carpeta de investigación correspondiente.

del sistema de despacho. Dada la inexistencia de aviso legal alguno se procedió a la incautación. El lugar quedó bajo resguardo de la FGR, que mantiene una investigación abierta por el delito de Almacenamiento de Hidrocarburo, previsto y sancionado en la Ley Federal para Prevenir y Sancionar los Delitos Cometidos en Materia de Hidrocarburos.

amorosa obligaron a la intervención de policías en una joyería

ubicada en la zona centro de la ciudad, cuyo propietario resultó ser la parte afectada.
Los hechos ocurrieron el viernes en un establecimiento ubicado en la calle Pino Suárez, justo frente a la Plaza IV Centenario, cuando su dueño se preparaba para cerrar el negocio, pues estaban por dar las 20:00 horas.
Antes de que eso ocurriera llegó su ex pareja de 49 años y comenzó con una serie de reclamos relacionados con la relación que tuvieron durante algunos años.
La fémina se tornó cada vez más agresiva, por lo que testigos decidieron pedir ayuda a través del número de emergencias y poco después llegó a la escena personal de la Policía Municipal.
Dado que el varón no desea más problemas con la mujer, pidió a los agentes que solo la alejaran del establecimiento, por lo que tras un rato de diálogo la persuadieron para que se retirara del lugar.






Iga Swiatek se coronó campeona de Wimbledon 2025 tras vencer a Amanda Anisimova en una final que quedará marcada en la historia del torneo. El triunfo de la polaca por doble 6-0 ocurre en un contexto único: en los últimos nueve años, nueve jugadoras diferentes han levantado el título femenil, confirmando el cierre de una era de hegemonías en el tenis femenil.
La polaca llegó a la final con una dominante victoria sobre Belinda Bencic, donde solo perdió dos games y rompió su maldición sobre césped, una superficie que durante años fue su punto débil. Tras más de un año sin títulos ni finales, encontró un nuevo estilo, más adaptado y paciente, y ya suma dos finales consecutivas sobre pasto. Este sábado logró su sexto Grand Slam y el primero en Wimbledon.
Del otro lado, Anisimova protagonizó una de las historias más impactantes del año. Alejada del circuito por cuestiones de salud mental, la estadounidense regresó con fuerza, claridad y madurez. En semifinales dio el golpe más fuerte del torneo al eliminar a la número uno del

mundo, Aryna Sabalenka, con la victoria más significativa de su carrera, pero no lo pudo convertir en su primer campeonato.
ADIÓS A LAS REINAS: NUEVE CAMPEONAS DI-

FERENTES
Serena Williams logró su séptimo y último título en Wimbledon en 2016. Desde entonces, ninguna jugadora ha repetido como campeona en La Catedral del Tenis. En los años siguientes, el trofeo femenino ha sido ganado por diferentes tenistas: Garbiñe Muguruza (2017), Angelique Kerber (2018), Simona Halep (2019), Ash Barty (2021), Elena Rybakina (2022), Marketa Vondrousova (2023), Barbora Krejcikova (2024) y, en 2025, Swiatek.
Sin embargo, la historia de Wimbledon femenil, que arrancó en 1884, está marcada por etapas de dominio absoluto, con figuras que impusieron dinastías legendarias.
En el siglo XIX y principios del XX, las británicas Lottie Dod (5 títulos) y Blanche Hillyard (6 títulos) marcaron el paso. Les siguieron Charlotte Sterry (5) y Dorothea Lambert Chambers (7) antes de la Primera Guerra Mundial.
Después de la pausa por el conflicto bélico, llegó la primera gran figura internacional: Su-
zanne Lenglen, quien conquistó seis campeonatos entre 1919 y 1925, incluyendo cinco de manera consecutiva.
LA ERA DE LOS DOMINIOS
En los años 30 surgió Helen Moody, que elevó el estándar con ocho victorias entre 1927 y 1938. Tras la Segunda Guerra Mundial, el dominio se fragmentó, pero nombres como Louise Brough (4), Maureen Connolly (3) y Maria Bueno (3) mantuvieron la tradición ganadora. A partir de 1966, comenzó la etapa dorada de Billie Jean King, quien conquistó seis coronas. Luego llegó la figura más dominante de todas: Martina Navratilova, la única tenista en la historia, entre hombres y mujeres, en levantar nueve títulos individuales en Wimbledon. Su dominio incluyó una racha de seis campeonatos consecutivos.
En los años 90, Steffi Graf tomó la estafeta con siete campeonatos. Y ya en el siglo XXI, la hegemonía pasó a las hermanas Williams. Venus ganó cinco
y Serena levantó siete. Entre 2000 y 2016, las hermanas fueron las protagonistas absolutas, incluso enfrentándose en cuatro finales.
CAMBIO DE GUARDIA
Desde 2017, el panorama en Wimbledon cambió drásticamente. Muguruza, Kerber y Halep rompieron con la era de dominio sostenido y abrieron paso a una etapa marcada por la rotación de campeonas. Ninguna logró establecer una racha prolongada, y la regularidad dio paso a la sorpresa.
Tras la pausa por la pandemia en 2020, la tendencia se acentuó. Ash Barty se coronó en 2021 y se retiró poco después. En 2022, Rybakina logró su primer Major. Al año siguiente, Vondrousova sorprendió al convertirse en la primera campeona no sembrada en la historia del torneo y en 2024, su compatriota Krejcikova levantó el trofeo desde el puesto 31 del ranking. En 2025, Swiatek se sumó a esta lista como nueva campeona.

Las Águilas del América no tuvieron el debut deseado en el Apertura 2025. La escuadra de André Jardine no logró conservar la ventaja obtenida en su visita al Olímpico Benito Juárez y por el contrario pasó momentos de angustia en los minutos finales del cotejo. El FC Juárez vino de menos a más en su casa; y con gol de Rodolfo Pizarro quien volvió a anotar en la Liga MX después de casi tres años, consiguió el empate en el arranque de actividades del fútbol mexicano.
Tanto el conjunto local como el visitante mostraron las carencias características de un partido de jornada 1 en el arranque del cotejo. Ni ‘Bravos’ ni ‘Águilas’ lograron tener profundidad y el
partido se desarrollo en medio campo. Lo más destacable en los primeros minutos fue la falta de Sebastián Cáceres sobre Madson de Souza, misma que lo hizo acreedor a la tarjeta amarilla apenas al minuto 4.
Poco a poco fue el actual subcampeón del torneo el que empezó a tener más iniciativa en el cotejo y a tener un poco más de acercamiento al frente, siendo Alejandro Zendejas el que más cerca se quedó del gol con un remate al 12’, mismo que se terminó por ir desviado de la meta de Sebastián Jurado.
Si bien no generó una presión mayor, el América logró abrir el marcador gracias a la técnica individual de su nuevo número ‘10’.
Un pase a profundidad de parte de Brian Rodríguez cerca del medio campo dejó a Zendejas en mano a mano ante Jurado por el costado de la derecha. El atacante americanista definió ante la salida del meta y le dio la ventaja a los suyos antes de los 45 minutos. El segundo tiempo parecía mostrar una mejor imagen del flamante tricampeón del fútbol mexicano. Remate de Cáceres estrellado en el travesaño y par de opciones de Rodrigo Aguirre parecían certificarlo, sin embargo una entrada desmedida de Erick Sánchez sobre Madson hizo que el silbante, tras chequeo en el VAR, decida expulsar al capitán americanista.
El timonel brasileño decidió
hacer modificaciones en su alineación al verse en inferioridad numérica, esperando no perder vocación ofensiva. En su esfuerzo mandó a Víctor Dávila y a Álvaro Fidalgo al campo, sin embargo, el español salió del campo tras menos de 10 minutos de acción debido a una lesión en la rodilla. Previo a su salida, los Bravos si lograron hacer valer sus modificaciones. Martín Varini ingresó al terreno a Rodolfo Pizarro y el mexicano respondió a la confianza al 80’ tras rematar de cabeza en el área y vencer así a Rodolfo Cota. Con este tanto, el flamante refuerzo de los fronterizos vuelve a aparecer como goleador en la Liga MX, tras no hacerlo desde el 22 de marzo del 2022 cuando
jugaba bajo la disciplina de los Rayados de Monterrey, en duelo precisamente ante los juarenses. Gracias al gol, los locales se lanzaron con todo al frente en busca de la ansiada victoria, sin embargo el reloj no fue benévolo con ellos, por lo que se tuvieron que conformar con la repartición de puntos ante su gente en este arranque de la fecha 1. Para la jornada 2, el FC Juárez tendrá una visita complicada al Estadio Universitario para enfrentar a los Tigres de la Autónoma de Nuevo León, mientras que el América debutará en casa recibiendo a los Xolos de Tijuana.
Tijuana arrancó con el pie derecho el torneo Apertura 2025 de la Liga MX al imponerse por la mínima diferencia de 1-0 ante Querétaro, en duelo correspondiente a la jornada 1. El único tanto del encuentro llegó poco antes del descanso, gracias a un autogol del defensor Omar Mendoza, quien desvió el balón hacia su propia portería en una desafortunada jugada. Después del tanto, el encuentro mantuvo un ritmo parejo, con pocas ocasiones claras para ambos equipos. La oportunidad más destacada del complemento la tuvo Gilberto Mora, quien sigue mostrando buen momento futbolístico. El delantero de Tijuana sacó un potente remate de derecha desde fuera del área, que fue detenido por el arquero queretano sin mayores complicaciones. Con este resultado, los Xolos suman sus primeros tres puntos del torneo y confirman el buen momento de su referente ofensivo de 16 años. Por su parte, Querétaro tendrá que ajustar su defensa si quiere recuperarse en la siguiente jornada tras este amargo debut.

Atlas gana dos años después en un arranque de torneo, luego de vencer al Puebla a domicilio Atlas comenzó con el pie derecho el torneo Apertura 2025 al imponerse 3-2 a Puebla en el Es-
tadio Cuauhtémoc. Los goles de Gaddi Aguirre, Rivaldo Lozano y Adrián Mora marcaron el rumbo del encuentro para los dirigidos por Gonzalo Pineda, mientras que Esteban Lozano y Edgar Guerra descontaron para los loca-
les, que buscaron revertir el marcador hasta el último minuto. La Franja cerró el duelo con múltiples aproximaciones, incluyendo remates de Efraín Orona que rozaron el empate en el tiempo añadido, pero el esfuerzo no
fue suficiente. Con esta victoria, Atlas sumó sus primeros tres puntos en la campaña, resistiendo la presión final del conjunto de Pablo Guede, que deberá ajustar para su siguiente compromiso en la Liga MX.

Isaac del Toro suma su tercera victoria consecutiva en la Vuelta a Austria 2025 al ganar la cuarta y penúltima etapa de la competencia, con lo que se consolidó en la cima de la clasificación general. El mexicano cruzó la meta con un tiempo de 3:27:20 en una jornada de alta montaña de 117,3 kilómetros entre las localidades tirolesas de Innsbruck y Kühtai.
A sus 21 años, volvió a demostrar su alto nivel competitivo en Austria, donde el UAE Team Emirates sigue dominando al ganar las etapas restantes. Felix Grossschartner cedió el liderato ante el imponente ritmo que mantenía el pelotón principal, sin embargo el conjunto de Emiratos Árabes no se mostró en apuros, ya que Rafal Majka tomó el control en la subida decisiva, preparando el terreno para su compañero, Del Toro. Archie Ryan, quien está a 29 segundos del mexicano fue el único que pudo mantener el ritmo de la dupla del UAE hasta los últimos metros.
Pero en el sprint por la victoria, el mexicano mostró el poder de sus piernas. Con una potente salida, Del Toro se escapó para asegurar otra victoria y terminar cono líder de la clasificación general. Archie Ryan de Irlanda fue segundo con solo cuatro segundos por detrás del mexica-

no, mientras que Rafal Majka fue tercero a seis segundos. En el top cinco también figuró el colombiano Jhoan Chaves de Pro Cycling Stats, quien terminó a 34 segundos.
DEL TORO, ORGULLOSO POR EL TRABAJO EN EQUIPO
Felix Grossschartner cayó considerablemente ene la clasificación, algo que lamentó el mexicano: “No tiene como el mejor sentimiento en la final de la segunda línea. Intentamos estar un poco con él, pero al final la subida era cada vez más empinada y logramos tener más control de la carrera y
también meter más presión a los otros equipos. Así que si es aún más difícil, ellos están más cansados. Y sí, es una pena porque realmente queríamos ver a Felix hacerlo, pero cualquiera puede tener o no tener un mal día. Pero pudimos hacerlo con el equipo y estamos orgullosos de ello”. Del Toro y Rafael Ma-

jka se mantienen en el top 5 de la general: “Sí. Es bueno estar en esta posición y seguro que intentaremos disfrutar de esto”. Sobre ganar mañana, confesó: “Sí. Veamos. No lo sé. Uh, no lo creo, pero ya veremos”.
CLASIFICACIÓN DE LA ETAPA 4 DE LA VUELTA A AUSTRIA
Isaac del Toro | México | UAE Team Emirates-XRG | 3:27:20
Archie Ryan | Irlanda | EF Education-EasyPost | a 0:04
Rafal Majka | Polonia | UAE Team Emirates-XGR | a 0:06
Felix Engelhardt | Alemania | Jayco-AlUla | a 0:25
Jhoan Chaves | Colombia | Pro Cycling Stats | 0:34
CLASIFICACIÓN GENERAL DE LA VUELTA A AUSTRIA
Isaac del Toro | México | UAE Team Emirates-XRG | 13:58:08
Archie Ryan | Irlanda | EF Education-EasyPost | a 0:29
Rafal Majka | Polonia | UAE Team Emirates-XGR | a 0:47
Felix Engelhardt | Alemania | Jayco-AlUla | a 1:20 Andrew August | Estados Unidos | Ineos Grenadiers | a 1:47

Álvaro Angulo ya está en territorio mexicano. El lateral izquierdo colombiano arribó este sábado al Aeropuerto Internacional de la Ciudad de México con la intención de convertirse en nuevo jugador de los Pumas de la UNAM para el torneo Apertura 2025. Por ahora, su incorporación no es oficial, ya que deberá someterse a exámenes médicos este mismo día y completar pruebas físicas el domingo. Solo si las supera, podrá ser anunciado como refuerzo universitario.
A su llegada, el defensor, de reciente paso por Independiente de Avellaneda en Argentina, ofreció sus primeras palabras en suelo mexicano.
“Sí, estoy feliz de estar acá. Me voy a encontrar con un cuerpo técnico que ya tuve, con Efraín Juárez, donde me fue bien
deportiva mente, en Nacional. Y nada, también sé de la institución donde llego, Pumas, un equipo grande en México y bueno, espero estar a la altura de lo que hago”, declaró ante medios. Angulo ya trabajó con Efraín
Juárez en Atlético Nacional de Colombia y no dudó en reconocer que el hoy técnico de Pumas fue clave para tomar esta decisión.
“La influencia de Efraín fue vital. Hablé con él desde el principio, me mostró el interés que tenía de tenerme en Pumas y desde el primer momento acepté”.
Sobre su conocimiento del fútbol mexicano y del equipo, el colombiano dejó claro que llega con referencias claras: “Cuando estaba en Colombia miraba mucho la liga, por los compatriotas, y sé que es uno de los equipos
más grandes. Creo que está entre los cuatro más grandes. Sé también que hace mucho tiempo no ha ganado el título y creo que esa es la exigencia para este año”. Finalmente, se dijo ilusionado por compartir vestidor con figuras como Aaron Ramsey: “Cuando miré la contratación de Ramsey, me emocioné también un poco más. Y nada, ahora compartir con él, llevar una buena amistad y al final, dar lo que es”. Antes de retirarse del aeropuerto, envió un mensaje para la afición universitaria: “Una vez más me comprometo que de Álvaro Angulo esperarán el cien por ciento. Quiero dar lo mejor y también hacer cosas buenas para esta institución. Sé que merecen solo alegría”.



